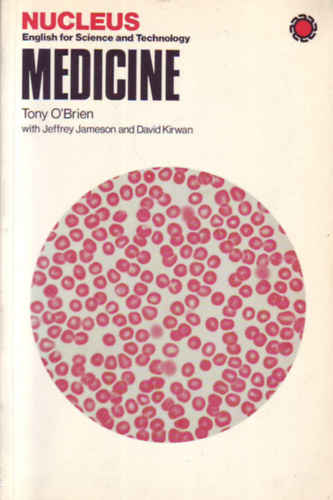
T. O'Brien; J. Jameson; D. Kirwan - Nucleus English for Science and Technology Medicine

Ajándék - Egyéb
0 | longman | 1991
Szállítási idő:
6-8 munkanap
200 pontot ér
0 | európa könyvkiadó | 1991
Kétnyelvű.
Szállítási idő:
4-6 munkanap
299 pontot ér
0 | dh-press | 1991
Szállítási idő:
4-6 munkanap
94 pontot ér
0 | bibliaiskolák közössége | 1991
Szállítási idő:
6-8 munkanap
145 pontot ér
0 | fischer taschenbuch verlag | 1991
Szállítási idő:
4-6 munkanap
229 pontot ér
0 | century books | 1991
Most managers know that revitalization in their companies must occur from the ground up. But how to...
Szállítási idő:
6-8 munkanap
459 pontot ér
0 | longman | 1991
Szállítási idő:
6-8 munkanap
168 pontot ér
0 | rowohlt | 1991
Roald Dahl und andere Autoren
Szállítási idő:
6-8 munkanap
220 pontot ér
0 | ismeretlen | 1991
Szállítási idő:
6-8 munkanap
129 pontot ér
0 | xenos | 1991
Szállítási idő:
6-8 munkanap
190 pontot ér
0 | co-nexus print-ter kft. | 1991
Szállítási idő:
6-8 munkanap
109 pontot ér
0 | minerva | 1991
Szállítási idő:
6-8 munkanap
268 pontot ér
0 | xenos | 1991
Szállítási idő:
6-8 munkanap
220 pontot ér
0 | xenos | 1991
Szállítási idő:
6-8 munkanap
220 pontot ér
0 | xenos | 1991
Szállítási idő:
6-8 munkanap
220 pontot ér
0 | xenos | 1991
Szállítási idő:
6-8 munkanap
220 pontot ér
0 | coronet books | 1991
Szállítási idő:
6-8 munkanap
220 pontot ér
0 | lsi oktatóközpont | 1991
Szállítási idő:
4-6 munkanap
135 pontot ér
0 | bolyai jános matematikai társulat | 1991
5#. Á. Császár Topics in topology 12#, Prékopa Progress in operations research Vol. I.-II...
Szállítási idő:
6-8 munkanap
2389 pontot ér
0 | európa könyvkiadó | 1991
Szállítási idő:
4-6 munkanap
125 pontot ér